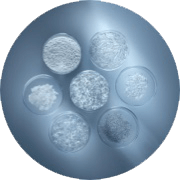

مستحلب كلاريفيك المائي
يمتاز هذا المستحلب بتركيبة مفتّحة للبشرة، تمّ تعزيزها بخلاصة براعم الزان الفرنسي، فضلاً عن مشتق ... قراءة الوصف الكامل
PDP Tabs
PDP Slot 1 Section
PDP Section FAQ
فوائد المستحضر
يمتاز هذا المستحلب بتركيبة مفتّحة للبشرة، تمّ تعزيزها بخلاصة براعم الزان الفرنسي، فضلاً عن مشتق الفيتامين سي والنياسيناميد، لتزداد البشرة إشراقاً ويتوحّد لونها بشكل ملحوظ.
فتستفيد من ترطيبٍ فوري يدوم حتّى 24 ساعة، وتبدو مرتاحة ولونها موحّد.
كذلك، تغدو البشرة أكثر نقاءً وتستعيد توازنها، فتتقلّص مسامها ويتحسّن قوامها وتزيد نعومتها.